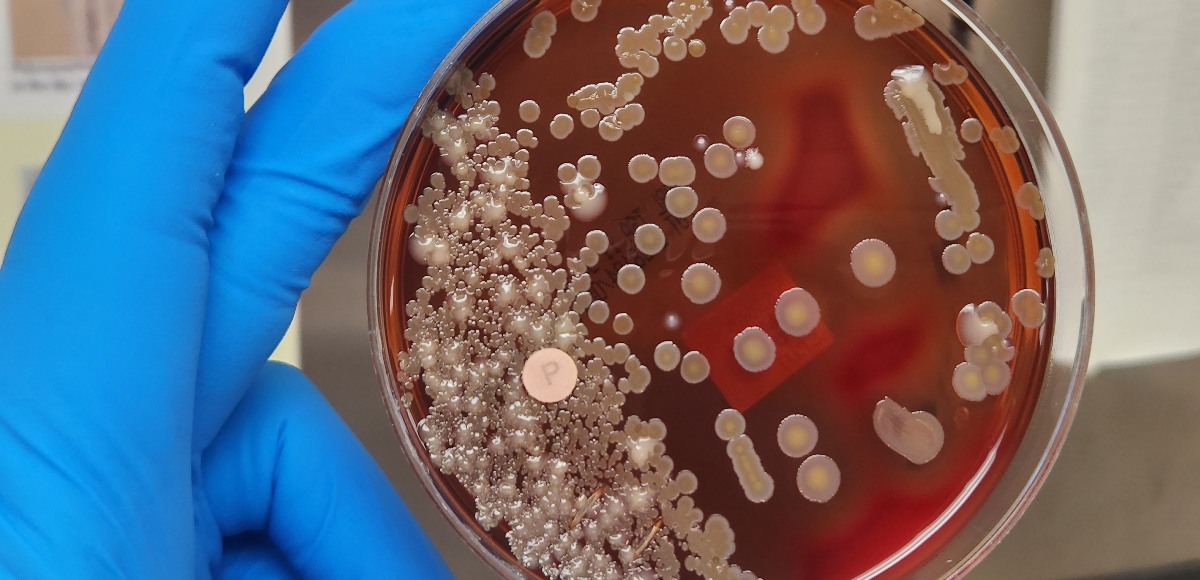
anticorpi anca

Questo esame di laboratorio permette di identificare e quantificare le diverse popolazioni di linfociti presenti nel sangue: viene solitamente prescritta per il monitoraggio di pazienti con infezione da HIV e per la diagnosi di malattie autoimmuni
Esami del sangue (Analiti)
Cosa sono gli anticorpi anti mitocondrio e quando fare il test
Gli anticorpi anti mitocondrio sono immunoglobuline, principalmente di classe IgG e IgM, dirette contro antigeni presenti nella membrana interna dei mitocondri
Che cos’è il DAO Test: come funziona e a cosa serve
Il DAO test è un’analisi di laboratorio che valuta la concentrazione e l’attività dell’enzima diaminossidasi nel sangue
IGRA test: cos’è e a cosa serve
Il test IGRA (Interferon-Gamma Release Assay) è un esame del sangue per diagnosticare l’infezione tubercolare latente. Misura la risposta immunitaria al Mycobacterium tuberculosis, offrendo un’alternativa più specifica al tradizionale test Mantoux
Anticorpi ANCA: cosa sono, quando dosarli e cosa indicano
Gli anticorpi ANCA sono autoanticorpi, ovvero anticorpi che il sistema immunitario produce erroneamente contro componenti del proprio organismo
Acidi biliari e acido ursodesossicolico
La analisi per gli acidi biliari sono uno strumento diagnostico fondamentale per comprendere lo stato di salute, e la funzionalità, del fegato.
Emoglobina
Scopri cos’è l’emoglobina, come misurarla, quando consultare un medico e come mantenerla nei valori normali con alimentazione e integratori
Anticorpi anti muscolo liscio
Gli anticorpi anti muscolo liscio sono autoanticorpi che attaccano il fegato. La loro presenza può indicare epatite autoimmune o altre patologie epatiche.
APCA – Anticorpi anticellule parietali gastriche
Il test degli anticorpi anti-cellule parietali (APCA) rileva autoimmunità gastrica utile per diagnosticare gastrite atrofica e anemia perniciosa da carenza di B12.
IgE specifiche: alternaria alternata
Il test IgE per Alternaria alternata identifica la sensibilizzazione a una muffa comune, causa di rinite, asma e altre allergie respiratorie.